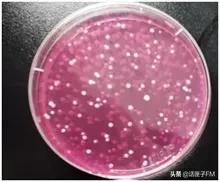
面膜菌落超标不合格的原因,面膜菌落超标

你是不是也和我一样
好喜欢 囤 (浪) 面 (费) 膜 (钱)

结果,一不小心...
不少面膜就过期了
有人不在意面膜的有效期限
觉得只要没干就能敷
那么,过期面膜能用吗?
市消保委组织专业机构进行微生物测试
结果发现——
消费者用面膜一定要 留意保质期

市消保委收集了5款不同品牌过期面膜
(面膜都已过期,无关产品质量)
分别具有补水、美白、修护等功效
检测过程严谨且专业

测试结果显示——
有两款产品菌落总数超标
一款过期了4年2个月
菌落总数为5.5万CFU/g
(表示1克检样中含有细菌菌落5.5万个)
霉菌总数为5.9万CFU/g
(表示1克检样中含有霉菌5.9万个)
一款过期了3个月
菌落总数大于30万CFU/g
(表示1克检样中含有细菌菌落30万个)

菌落总数与面膜过期长短
未必成正比
过期时间短的面膜中
菌落总数
可能比过期时间长的面膜更多
我们来科普一下
根据我国化妆品安全技术规范
眼部化妆品、口唇化妆品和儿童化妆品的
菌落总数不得超过500CFU/g
其他普通化妆品的菌落总数不超过1000CFU/g
霉菌和酵母菌总数不超过100CFU/g
由此得出
一款过期面膜的细菌数量
是标准的300倍!!!
长满霉菌和酵母菌的培养皿

长满菌落的培养皿近景
专业意见
菌落指数超标容易导致面膜的营养成分被破坏;
消费者如使用过期面膜,可能会引起细菌感染,产生过敏;
面膜使用时距离眼睛等易感染位置较近,也容易引发这些部位感染。

市消保委建议消费者
在有效期内使用面膜
谁也不想越敷越糟糕
不要让可能危害到肌肤的事情发生
本文图片来自市消保委
作者:上海电台记者胡旻珏
